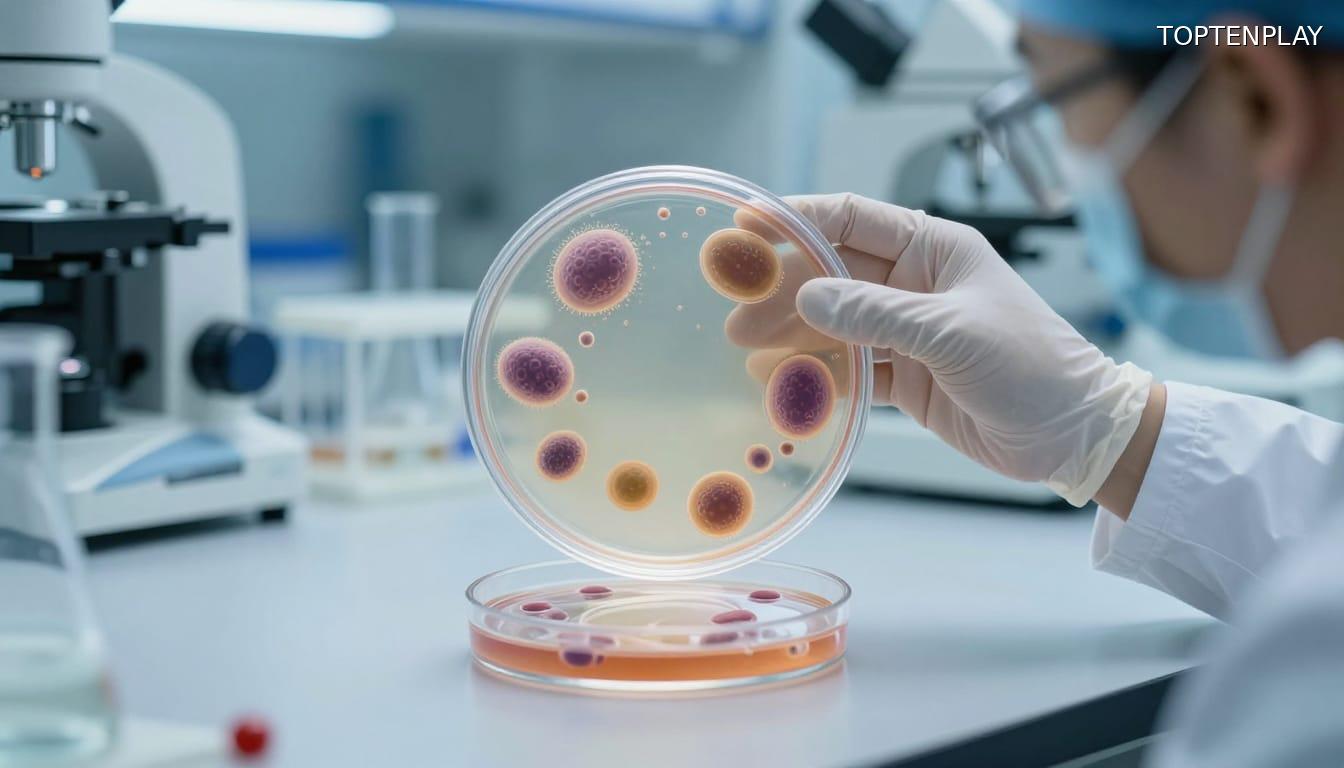
Image d'illustration © TopTenPlay

📌 Méningite bactérienne : céphalées intenses, vomissements en jet et purpura, les 3 signaux d’urgence vitale à ne jamais ignorer

Posted 25 mars 2026 by: Admin

La Menace Silencieuse : Quand Un Simple Mal De Tête Peut Tuer En Moins De 24h
Un mal de crâne inhabituel après une soirée entre amis, une fièvre qui grimpe, une fatigue écrasante : pour beaucoup, ces signaux évoquent un banal virus saisonnier. Pourtant, derrière cette apparence trompeuse peut se cacher une méningite bactérienne, capable de tuer un adulte en pleine santé en moins de vingt-quatre heures. Cette confusion fatale retarde le diagnostic au moment précis où chaque minute compte.
La bactérie Neisseria meningitidis, le méningocoque, colonise discrètement le nez ou la gorge d’environ 10 % de la population sans provoquer le moindre symptôme. Ces porteurs sains deviennent des vecteurs involontaires : une simple conversation, un éclat de rire en soirée ou dans un foyer étudiant suffit à propager les gouttelettes infectieuses. Lorsque le germe franchit la barrière sanguine et atteint les méninges, l’inflammation explose avec une rapidité foudroyante.
L’Organisation Mondiale de la Santé révèle des chiffres glaçants : une personne sur six atteinte de méningite bactérienne décède, une sur cinq conserve des séquelles neurologiques graves. En France, la létalité atteint 20 %, avec autant de survivants marqués à vie par des handicaps moteurs, cognitifs ou sensoriels irréversibles.
Les populations les plus vulnérables forment un cercle inquiétant : nourrissons aux défenses immatures, adolescents et jeunes adultes de 15 à 24 ans vivant en collectivité, personnes âgées au système immunitaire affaibli. Pour eux, la marge entre un début d’infection et l’issue fatale se compte en heures, pas en jours.
Flambée Inquiétante : +72% De Cas En Un An Et Un Décès Récent À Cherbourg
Cette menace silencieuse connaît une résurgence alarmante. En France, les infections invasives à méningocoque ont bondi de 72 % en 2023 par rapport à 2022, sortant brutalement d’une période de calme relatif. Les souches W et Y, jusqu’alors minoritaires, progressent dangereusement aux côtés du méningocoque B qui reste dominant. Leur particularité : un taux de létalité pouvant atteindre 20 %, soit un décès sur cinq parmi les personnes infectées.
Outre-Manche, des clusters ont été signalés en Angleterre, créant une alerte transfrontalière qui oblige les autorités sanitaires françaises à renforcer leur vigilance. La transmission par gouttelettes respiratoires lors de rassemblements sociaux, en caserne ou en foyer étudiant explique cette propagation rapide dans les collectivités où les contacts sont étroits et prolongés.
Le 19 mars 2026 à Cherbourg, une femme est décédée d’une forme foudroyante de méningite bactérienne. Ce cas récent illustre avec une cruauté implacable la vitesse d’évolution de l’infection : une fois la bactérie installée dans les méninges, l’inflammation devient fulgurante et le système immunitaire, même chez un adulte en bonne santé apparente, se trouve dépassé en quelques heures.
Cette flambée épidémiologique soulève une question vitale : comment reconnaître à temps les symptômes qui distinguent cette urgence absolue d’une simple grippe ?

La Triade Mortelle : Les 3 Symptômes Qui Ne Pardonnent Pas
Face à cette urgence qui progresse en quelques heures, trois signaux d’alarme doivent déclencher un réflexe immédiat. Le premier : des céphalées d’une intensité inhabituelle, radicalement différentes d’une migraine ordinaire, qui résistent aux antalgiques habituels. Elles s’accompagnent d’une fièvre élevée et d’une photophobie marquée. Chez l’adulte, la nuque devient raide, pencher la tête en avant provoque une douleur vive : c’est le syndrome méningé.
Deuxième signal : les vomissements en jet, brutaux, sans lien avec un repas et sans diarrhée associée. Ils surviennent avec une confusion croissante, une somnolence inquiétante, des difficultés à répondre aux questions simples. Chez le nourrisson, on observe une mollesse anormale, un bébé qui se réveille difficilement, refuse de s’alimenter et présente une fontanelle bombée.
Le troisième symptôme, le plus redoutable, ne touche que 30 % des cas mais signe une catastrophe imminente : le purpura fulminans. Ces petites taches rouges ou violacées sur la peau ne pâlissent pas lorsqu’on applique un verre transparent dessus. Ce signe traduit une septicémie gravissime pouvant conduire à l’amputation de membres si l’intervention tarde.
Cette triade fièvre-céphalées-vomissements avec ou sans purpura ne laisse aucune place à l’attente. Chaque minute perdue réduit les chances de survie sans séquelles.

Urgence Absolue : Le Protocole Qui Sauve Et La Prévention Désormais Obligatoire
Face à ces symptômes, le réflexe ne souffre aucune hésitation : composer immédiatement le 15 (SAMU) ou le 112. Décrire précisément les signes observés permet aux régulateurs d’évaluer la gravité et de déclencher une intervention prioritaire. Les équipes médicales n’attendent pas : dès la suspicion de méningite bactérienne, l’antibiothérapie démarre avant même les résultats de la ponction lombaire. Cette anticipation fait la différence entre la vie et la mort.
Le protocole hospitalier combine traitement antibiotique massif, ponction lombaire pour identifier la souche responsable et surveillance en réanimation si l’état neurologique se dégrade. Chaque heure gagnée réduit le risque de séquelles irréversibles ou d’issue fatale.
Depuis le 1er janvier 2025, la France a franchi un cap préventif décisif : les vaccins contre le méningocoque B et les sérogroupes A, C, W, Y sont devenus obligatoires pour tous les nourrissons. Cette mesure vise à protéger les plus vulnérables dès les premiers mois de vie. Pour les adolescents de 15 à 24 ans vivant en collectivité et les personnes immunodéprimées, la vaccination reste vivement recommandée.
Mais aucun vaccin n’offre une protection absolue. Connaître la triade mortelle fièvre-céphalées-vomissements et savoir reconnaître un purpura qui ne pâlit pas au test du verre reste l’ultime rempart. Dans cette course contre la montre, l’information devient une arme de survie.




















